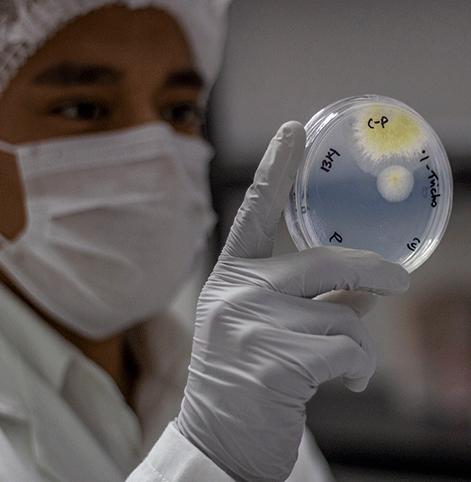

Adán Ramírez de 23 años decidió llevar su investigación en medios alternativos de energía más allá, creando el primer bio panel solar inteligente a base de algas marinas, proyecto que ahora junto con otros siete jóvenes representarán a México entre las mentes más brillantes menores de 35 años de todo el mundo reconocidas por el Instituto de Tecnología de Massachusetts (MIT).
Egresado de la Universidad Autónoma del Estado de México (UAEM) y originario de Toluca, Adán menciona que el proyecto de los bio paneles solares inteligentes está basado en el uso de microalgas y nanopartículas, que a través de la luz solar se pueda generar energía, oxígeno y al mismo tiempo absorber el bióxido de carbono, por lo que comenzaron a buscar financiamiento familiar y en fondos de capital y concursos para poder financiarse.

La iniciativa en la que concursa el proyecto es el Innovators Under 35 Latam 2020, organizada por el MIT Technology Review y Opinno, quienes publican una lista de los jóvenes menores de 35 años con ideas que cambien el futuro del planeta. Entre los premiados en las ediciones previas a nivel global se encuentran Mark Zuckerberg, fundador de Facebook, Konstantin Novoselov, Premio Nobel de Física) y Max Levchin, cofundador de Paypal por crear iniciativas o desarrollar proyectos para resolver los problemas actuales del mundo agregando tecnología e innovación para afrontar de mejor manera los retos más importantes en materia social, económica y ambiental.
Beatriz Ferreira, directora de la consultora Opinno Latinoamérica, destacó que el objetivo es descubrir y presentar las ideas más creativas, inspiradora y revolucionarias en materia de tecnología, y a los jóvenes que la están haciendo posible, “Opinno como consultores de innovación y editores de MIT Tech Review en español somos los responsables de las ediciones en Latinoamérica y Europa, donde hemos premiado a más de 500 jóvenes”, señaló.
La directiva abundó que en esta nueva edición, a nivel regional se contó con más de 2 mil candidaturas de 15 países, diferenciándose en las categorías de emprendedores humanitarios, pioneros, visionarios e inventores. Los países que entregaron más propuestas fueron México con ocho proyectos, Colombia, Brasil, Chile, Argentina, Perú y Ecuador.

“Nos fijamos en un reto clave a resolver por parte de los 35 Innovadores menores de 35 años que elegimos como ganadores. Constantemente escuchamos la palabra innovación, pero no se refiere a la innovación únicamente como crear una solución que implique la invención de una tecnología, sino que aporte un valor a una problemática concreta aplicable a nivel global y que impacte en sectores vulnerables de la sociedad”, dijo.
En el caso de Adán, su proyecto ya se encuentra en el nivel de pruebas, por lo que aún no se comercializa; sin embargo, tienen planeado que para la mitad de este año se pongan a la venta, por lo que solo esperan una ronda de inversión que les ayude a poner en marcha la creación de los paneles, que cambia el diseño común de los paneles para que se puedan colocar como ventanas, tragaluz o muros principalmente en edificios sustentables, pero también para el uso doméstico.
“Ya hace casi tres años, junto con un amigo en la licenciatura quisimos ir más allá de quedarnos en la ciencia y en la investigación, entonces empezamos a ver cómo podríamos resolver el problema de llevar energía realmente sustentable a millones de personas y que retornara beneficios a la tierra, este impacta con el sol y las microalgas que son plantas chiquitas generan el oxígeno y absorben el dióxido de carbono”, indicó Adán.
Ferreira explicó que este año, la premiación cuenta con una amplia gama de verticales de proyectos, que van desde biotecnología, medicina, sustentabilidad, inteligencia artificial, software y hardware, entre otras, lo cual permite una gran variedad de ideas.
“Es interesante ver cómo los nuevos emprendedores están buscando soluciones que impacten en el medio ambiente, pues sabemos que estamos parados en una situación preocupante”, indicó la experta.
lvm